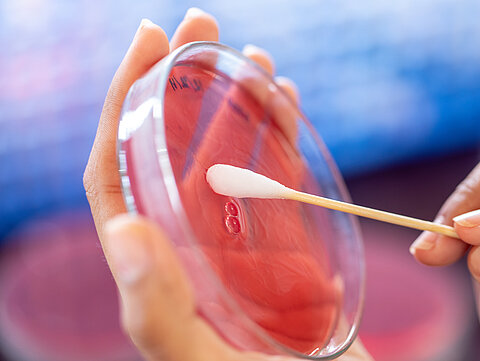

Neu in unserer Praxis!
Wir bieten einen Bluttest neben unserem Standard Stuhltest an, der zwar nicht direkt das Mikrobiom misst, dafür aber die Stoffwechselprodukte, die von den Darmbakterien produziert werden
Hierbei kann die funktionelle Leistung des Darms beurteilt werden.